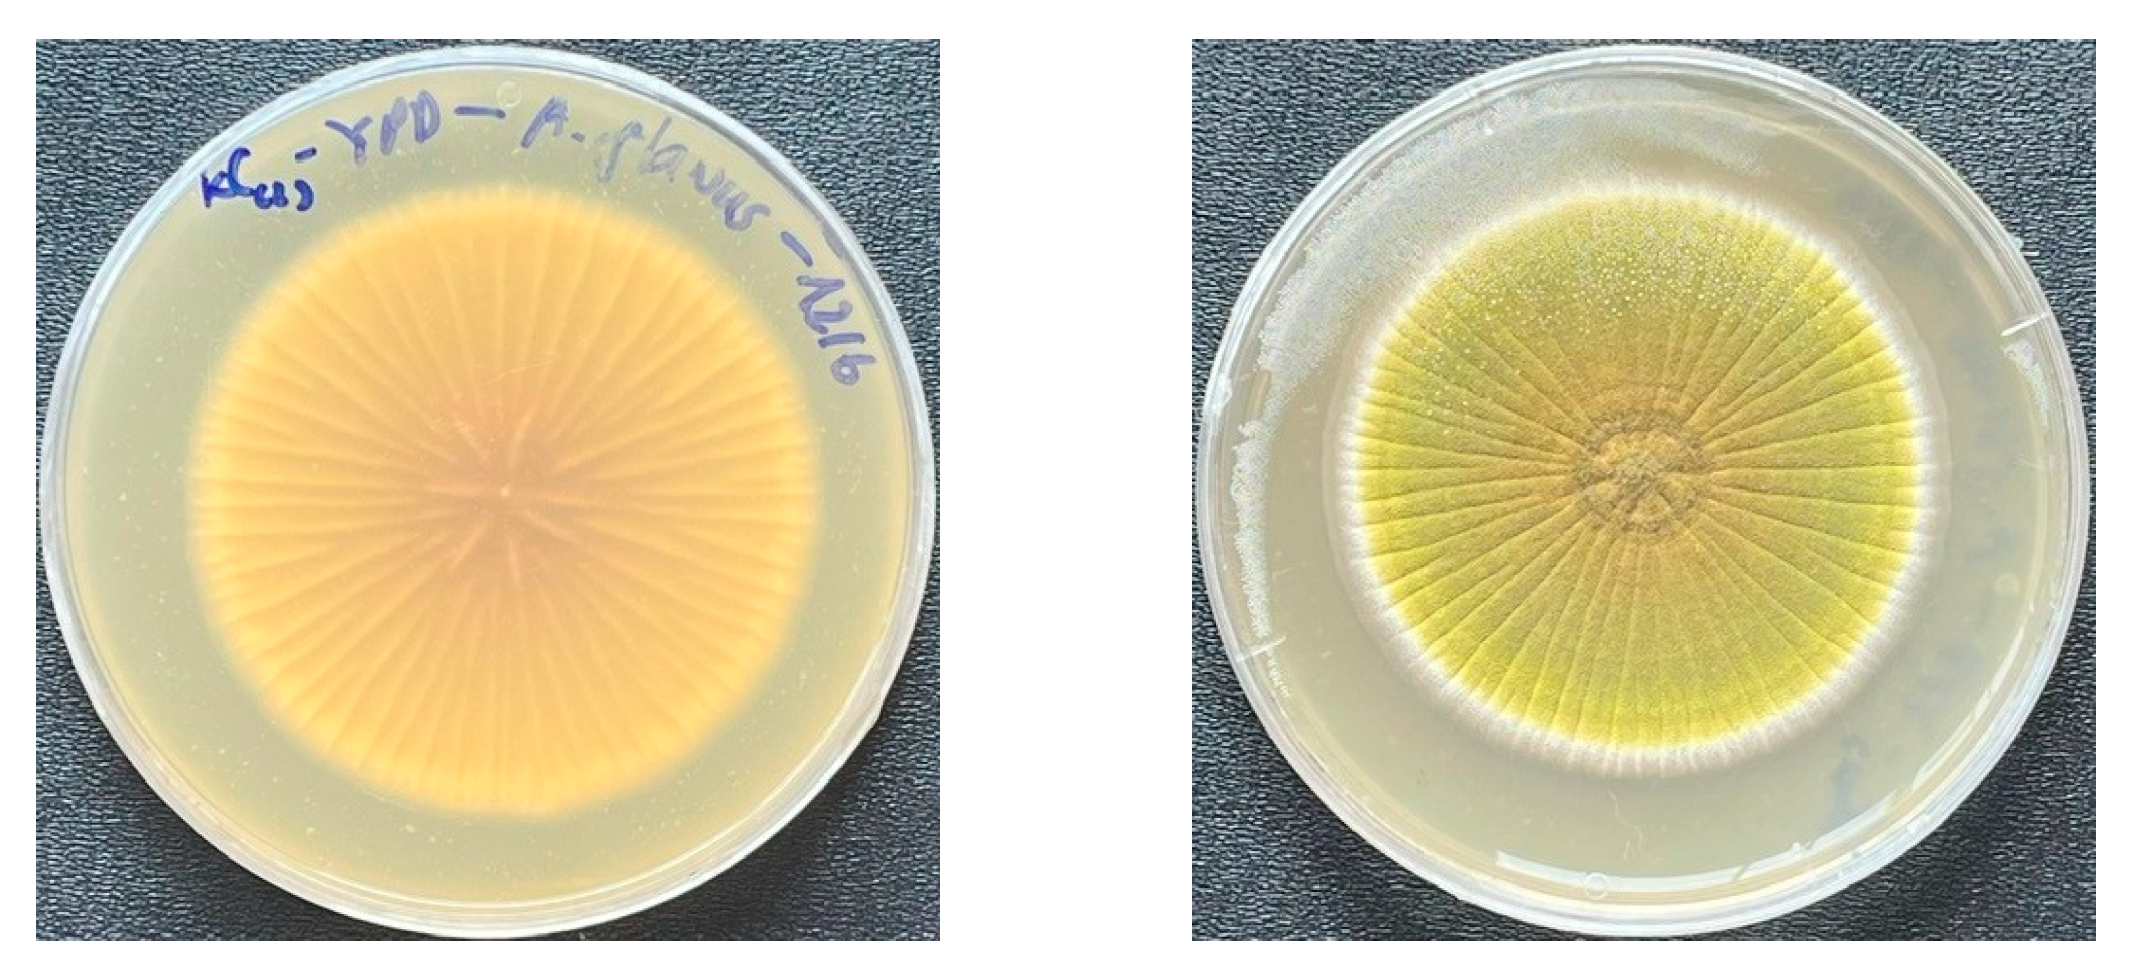
Microbiolres 16 00111 g001

Evaluation of Anti-Aspergillus flavus Activity of Lactic Acid Bacteria Isolated from Vietnamese Fermented Cocoa Beans
Abstract
1. Introduction
2. Materials and Methods
2.1. Materials
2.2. Methods
2.2.1. Micro-organism Cultivations
2.2.2. Evaluation of Antifungal Activity of LAB in Agar Plates
2.2.3. Determination of the Minimum Inhibitory Concentration (MIC) and the Minimum Fungicidal Concentration (MFC) of LAB’s Cell-Free Supernatant (CFS)
- Preparation of CFS
- Determination of the minimum inhibitory concentration (MIC) and the minimum fungicidal concentration (MFC)
2.2.4. pH, Total Titratable Acidity, and Organic Acid Profile in CFS
2.2.5. Strain Identification
2.2.6. Statistical Analysis
3. Results and Discussion
3.1. Evaluation of Antifungal Activity of LAB Strains on the Agar Plates
3.2. The Minimum Inhibitory Concentration and the Minimum Fungicidal Concentration of LAB’s Cell-Free Supernatant
3.2.1. pH, Total Titratable Acidity, and Organic Acid Profile of CFS
3.2.2. Minimum Inhibitory Concentration and Minimum Fungicidal Concentration
4. Conclusions
Author Contributions
Funding
Institutional Review Board Statement
Informed Consent Statement
Data Availability Statement
Conflicts of Interest
References
- Magro, A.; Carolino, M.; Bastos, M.; Mexia, A. Efficacy of plant extracts against stored products fungi. Rev. Iberoam. Micol. 2006, 23, 176–178. [Google Scholar] [CrossRef] [PubMed]
- Bullerman, L.B. SPOILAGE | Fungi in Food—An Overview. In Encyclopedia of Food Sciences and Nutrition; Academic Press: Cambridge, MA, USA, 2003; pp. 5511–5522. [Google Scholar] [CrossRef]
- Gacem, M.A.; Krantar, K.; Hadef, S.; Boudjemaa, B. Chapter 6—Secondary metabolites from lactic acid bacteria as a source of antifungal and antimycotoxigenic agents. In Bacterial Secondary Metabolites; Abd-Elsalam, K.A., Mohamed, H.I., Eds.; Elsevier: Amsterdam, The Netherlands, 2024; pp. 107–122. [Google Scholar]
- Zhang, Y.; Li, B.; Fu, M.; Wang, Z.; Chen, K.; Du, M.; Zalán, Z.; Hegyi, F.; Kan, J. Antifungal mechanisms of binary combinations of volatile organic compounds produced by lactic acid bacteria strains against Aspergillus flavus. Toxicon 2024, 243, 107749. [Google Scholar] [CrossRef] [PubMed]
- Shi, C.; Maktabdar, M. Lactic Acid Bacteria as Biopreservation Against Spoilage Molds in Dairy Products—A Review. Front. Microbiol. 2022, 12, 819684. [Google Scholar] [CrossRef]
- Siedler, S.; Balti, R.; Neves, A.R. Bioprotective mechanisms of lactic acid bacteria against fungal spoilage of food. Curr. Opin. Biotechnol. 2019, 56, 138–146. [Google Scholar] [CrossRef]
- Muhialdin, B.J.; Algboory, H.L.; Kadum, H.; Mohammed, N.K.; Saari, N.; Hassan, Z.; Meor Hussin, A.S. Antifungal activity determination for the peptides generated by Lactobacillus plantarum TE10 against Aspergillus flavus in maize seeds. Food Control 2020, 109, 106898. [Google Scholar] [CrossRef]
- Hassan, Y.I.; Bullerman, L.B. Antifungal activity of Lactobacillus paracasei ssp. tolerans isolated from a sourdough bread culture. Int. J. Food Microbiol. 2008, 121, 112–115. [Google Scholar] [CrossRef]
- Le Lay, C.; Mounier, J.; Vasseur, V.; Weill, A.; Le Blay, G.; Barbier, G.; Coton, E. In vitro and in situ screening of lactic acid bacteria and propionibacteria antifungal activities against bakery product spoilage molds. Food Control 2016, 60, 247–255. [Google Scholar] [CrossRef]
- Rouse, S.; Harnett, D.; Vaughan, A.; van Sinderen, D. Lactic acid bacteria with potential to eliminate fungal spoilage in foods. J. Appl. Microbiol. 2008, 104, 915–923. [Google Scholar] [CrossRef]
- Volentini, S.I.; Olmedo, G.M.; Grillo-Puertas, M.; Rapisarda, V.A.; Hebert, E.M.; Cerioni, L.; Villegas, J.M. Biological control of green and blue molds on postharvest lemon by lactic acid bacteria. Biol. Control 2023, 185, 105303. [Google Scholar] [CrossRef]
- Ryan, L.A.M.; Dal Bello, F.; Arendt, E.K. The use of sourdough fermented by antifungal LAB to reduce the amount of calcium propionate in bread. Int. J. Food Microbiol. 2008, 125, 274–278. [Google Scholar] [CrossRef]
- Agriopoulou, S.; Stamatelopoulou, E.; Sachadyn-Król, M.; Varzakas, T. Lactic Acid Bacteria as Antibacterial Agents to Extend the Shelf Life of Fresh and Minimally Processed Fruits and Vegetables: Quality and Safety Aspects. Microorganisms 2020, 8, 952. [Google Scholar] [CrossRef] [PubMed]
- Viesser, J.A.; de Melo Pereira, G.V.; de Carvalho Neto, D.P.; Favero, G.R.; de Carvalho, J.C.; Goés-Neto, A.; Rogez, H.; Soccol, C.R. Global cocoa fermentation microbiome: Revealing new taxa and microbial functions by next generation sequencing technologies. World J. Microbiol. Biotechnol. 2021, 37, 118. [Google Scholar] [CrossRef] [PubMed]
- Sánchez-Hervás, M.; Gil, J.V.; Bisbal, F.; Ramón, D.; Martínez-Culebras, P.V. Mycobiota and mycotoxin producing fungi from cocoa beans. Int. J. Food Microbiol. 2008, 125, 336–340. [Google Scholar] [CrossRef] [PubMed]
- Fusaro Ramon, M. Inoculation Technique for Fungus Cultures. Appl. Microbiol. 1972, 23, 174–176. [Google Scholar] [CrossRef]
- Gopalakrishnan, S.; Arigela, R.; Thyagarajan, S.; Raghunathan, R. Comparison and evaluation of enumeration methods for measurement of fungal spore emission. J. Aerosol Sci. 2022, 165, 106033. [Google Scholar] [CrossRef]
- Plascencia-Jatomea, M.; Susana, M.; Gómez, Y.; Velez-Haro, J.M. Chapter 8—Aspergillus spp. (Black Mold). In Postharvest Decay; Bautista-Baños, S., Ed.; Academic Press: San Diego, CA, USA, 2014; pp. 267–286. [Google Scholar]
- Harčárová, M.; Čonková, E.; Naď, P.; Váczi, P.; Proškovcová, M. In Vitro Inhibitory Activity of Cell-Free Supernatants of Lactobacillus spp. and Bacillus spp. Against Fusarium graminearum. Folia Vet. 2021, 65, 9–14. [Google Scholar] [CrossRef]
- Liu, H.; Zhang, R.; Zhang, Q.; Tian, M.; Ren, X.; Wang, L.; Wang, X. Antifungal Activity of Cell-Free Supernatants from Lactobacillus pentosus 86 against Alternaria gaisen. Horticulturae 2023, 9, 911. [Google Scholar] [CrossRef]
- Nazareth, T.M.; Luz, C.; Torrijos, R.; Quiles, J.M.; Luciano, F.B.; Mañes, J.; Meca, G. Potential Application of Lactic Acid Bacteria to Reduce Aflatoxin B1 and Fumonisin B1 Occurrence on Corn Kernels and Corn Ears. Toxins 2019, 12, 21. [Google Scholar] [CrossRef]
- William, S.; Feil, H.; Copeland, A. Bacterial Genomic DNA Isolationg Using CTAB; Version 3; JGI DOE Joint Genome Institute: Berkeley, CA, USA, 2012. Available online: https://scholar.google.com/scholar_lookup?title=Bacterial+genomic+DNA+isolation+using+CTAB&author=S+William&author=H+Feil&author=A+Copeland&publication_year=2012&journal=Sigma&pages=6876 (accessed on 7 April 2025).
- Mpeluza, A.S.; Akinola, S.A.; Shoko, T.; Remize, F.; Sivakumar, D. Efficacy of Lactic Acid Bacteria as a Biocontrol Agent against Anthracnose (Persea americana Miller) Decay in Avocado (Persea americana) cv Fuerte Fruit. Agriculture 2023, 13, 269. [Google Scholar] [CrossRef]
- Riolo, M.; Luz, C.; Santilli, E.; Meca, G.; Cacciola, S.O. Antifungal activity of selected lactic acid bacteria from olive drupes. Food Biosci. 2023, 52, 102422. [Google Scholar] [CrossRef]
- Russo, P.; Arena, M.P.; Fiocco, D.; Capozzi, V.; Drider, D.; Spano, G. Lactobacillus plantarum with broad antifungal activity: A promising approach to increase safety and shelf-life of cereal-based products. Int. J. Food Microbiol. 2017, 247, 48–54. [Google Scholar] [CrossRef]

| IR (%) | SD (Days) | Notation | Description |
|---|---|---|---|
| IR ≤ 25% | 0 day | (-) | No inhibition |
| 25% < IR ≤ 50% | 1–2 days | (+) | Low inhibition |
| 50% < IR ≤ 75% | 3–4 days | (++) | Moderate inhibition |
| IR > 75% | ≥5 days | (+++) | Significant inhibition |
| Strain | Diameter After 7 Days, mm | Inhibition Rate (IR), % | Spore-Forming Delay (SD) | Evaluation Based on IR | Evaluation Based on SD |
|---|---|---|---|---|---|
| Control | 73.67 ± 0.29 | ||||
| L2E48 | 60.17 ± 1.04 | 18.33 b ± 1.41 | 0 day | (-) | (-) |
| L4E48 | 59.67 ± 1.26 | 19.01 b ± 1.71 | 0 day | (-) | (-) |
| L11E48 | 52.33 ± 0.58 | 28.96 c,d ± 0.79 | 1–2 days | (+) | (+) |
| L13E48 | 2.00 ± 0.50 | 97.29 k ± 0.68 | ≥5 days | (+++) | (+++) |
| L17E48 | 37.83 ± 0.76 | 48.64 g ± 1.03 | 3–4 days | (+) | (++) |
| L22E48 | 37.83 ± 2.25 | 48.64 g ± 3.05 | 1–2 days | (+) | (+) |
| L23E48 | 45.50 ± 2.78 | 38.24 f ± 3.77 | 1–2 days | (+) | (+) |
| L7E96 | 1.00 ± 0.00 | 98.73 k ± 0.00 | ≥5 days | (+++) | (+++) |
| L22E96 | 1.03 ± 0.06 | 98.60 k ± 0.08 | ≥5 days | (+++) | (+++) |
| L23E96 | 53.67 ± 1.44 | 27.15 c,d ± 1.95 | 0 day | (+) | (-) |
| L24E96 | 65.47 ± 0.50 | 11.14 a ± 0.68 | 0 day | (-) | (-) |
| L41E96 | 14.10 ± 1.01 | 80.86 i ± 1.37 | ≥5 days | (+++) | (+++) |
| L42E96 | 54.50 ± 2.78 | 26.02 c,d ± 3.77 | 1–2 days | (+) | (+) |
| L43E96 | 28.33 ± 0.76 | 61.54 h ± 1.03 | 3–4 days | (++) | (++) |
| L44E96 | 55.50 ± 1.50 | 24.66 c ± 2.04 | 0 day | (-) | (-) |
| L3DN24 | 60.17 ± 0.76 | 18.33 b ± 1.03 | 0 day | (-) | (-) |
| L2DN120 | 0.90 ± 0.17 | 98.78 k ± 0.23 | ≥5 days | (+++) | (+++) |
| L4DN120 | 47.25 ± 0.35 | 35.86 e,f ± 0.48 | 1–2 days | (+) | (+) |
| L6DN120 | 51.17 ± 0.29 | 30.55 d,e ± 0.39 | 1–2 days | (+) | (+) |
| Strain | pH | Total Titrable Acidity (g Lactic Acid/L) |
|---|---|---|
| L13E48 | 4.24 b ± 0.03 | 12.75 a ± 0.26 |
| L7E96 | 3.85 a ± 0.01 | 19.80 c ± 0.45 |
| L22E96 | 4.37 c ± 0.02 | 15.60 b ± 0.26 |
| L41E96 | 3.80 a ± 0.03 | 21.45 d ± 0.52 |
| L2DN120 | 4.28 b ± 0.05 | 12.90 a ± 0.26 |
| Strain | L7E96 | L22E96 | L41E96 | L13E48 | L2DN120 |
|---|---|---|---|---|---|
| Lactic acid (g/L) | 23.0515 | 14.8905 | 24.8859 | 12.3889 | 16.2105 |
| Acetic acid (g/L) | 0.3877 | 0.4340 | 0.3766 | 0.3684 | 0.4941 |
| Propionic acid (g/L) | 0.0601 | 0.0476 | 0.0580 | 0.0542 | 0.0485 |
| Butyric acid (g/L) | n.d | 0.0710 | n.d | 0.2093 | 0.0366 |
| Formic acid (g/L) | n.d | n.d | n.d | n.d | n.d |
Disclaimer/Publisher’s Note: The statements, opinions and data contained in all publications are solely those of the individual author(s) and contributor(s) and not of MDPI and/or the editor(s). MDPI and/or the editor(s) disclaim responsibility for any injury to people or property resulting from any ideas, methods, instructions or products referred to in the content. |
© 2025 by the authors. Licensee MDPI, Basel, Switzerland. This article is an open access article distributed under the terms and conditions of the Creative Commons Attribution (CC BY) license (https://creativecommons.org/licenses/by/4.0/).
Share and Cite
Nguyen, T.C.; Hoang, T.T.; Nguyen, H.H. Evaluation of Anti-Aspergillus flavus Activity of Lactic Acid Bacteria Isolated from Vietnamese Fermented Cocoa Beans. Microbiol. Res. 2025, 16, 111. https://doi.org/10.3390/microbiolres16060111
Nguyen TC, Hoang TT, Nguyen HH. Evaluation of Anti-Aspergillus flavus Activity of Lactic Acid Bacteria Isolated from Vietnamese Fermented Cocoa Beans. Microbiology Research. 2025; 16(6):111. https://doi.org/10.3390/microbiolres16060111
Chicago/Turabian StyleNguyen, Tien Cuong, Thi Thao Hoang, and Hoang Hiep Nguyen. 2025. "Evaluation of Anti-Aspergillus flavus Activity of Lactic Acid Bacteria Isolated from Vietnamese Fermented Cocoa Beans" Microbiology Research 16, no. 6: 111. https://doi.org/10.3390/microbiolres16060111
APA StyleNguyen, T. C., Hoang, T. T., & Nguyen, H. H. (2025). Evaluation of Anti-Aspergillus flavus Activity of Lactic Acid Bacteria Isolated from Vietnamese Fermented Cocoa Beans. Microbiology Research, 16(6), 111. https://doi.org/10.3390/microbiolres16060111

